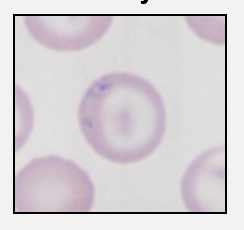

What is this vector?
What organisms are transmitted by it?

Rhipicephalus sanguineous (rips down its body)
E. canis and possibly anaplasma platys that run down its chalice
Rickettsia ricketssii (begins with an R)
What is this vector?

Dermacentor (the colour of the derm)
Ricketssia ricketsii
Babesia
Cytauxoon
What is this vector?

Ixodes (basic bitch)
Lyme
Anaplasma phagocytophilim
What is this vector?

Amblyoma - star in its centre, but no white like dermacentor (for the male)
E. chaffiensis and ewinggii (sounds like a chap and this is the poshest tick)
Cytauxoon and Hepatozoon americanum
This organism is isolated from the nasal cavity of a cat with URT signs, what is the organism, what distinguishes it from a related organism?

Cryptococcus, it is similar in appearance to blastomyces although the latter has a thinner wall and may be seen to be budding.
You isolate this organism from a lytic bone lesion in the distal limb of a cat, what is it?

A coccidiodes spherule
Draw a blastomyces organsism that may be found on cytology

Describe the appearance that may be seen for pythium species on histopathology?
Gomori’s methanamine silver may be useful to visualise hyphae that are poorly septate

What is this blood cell and what should it not be confused with?

This is an eccinocyte. It can look similar to acanthocyte (in this picture)

What does this picture indicate, what disease process may lead to its formation?

This is basophilic stippling of a RBC, this should raise concern for lead toxicity. The other finding that may be seen is a siderocyte
What are the two types of reticulocyte in cats, which is the clinically relevant one and how is it assessed?
Cats have punctate and aggregate reticulocytes.
Punctate Rt can be identified by staining with NMB
Aggregate reticulocytes are the one that most accurately reflect regeneration in cats.
What is the term for this RBC morphologic change and what does it indicate?
Other than this change, what other erythrocyte morphologic changes can be noted with similar pathologies?

This is an acanthocyte, it can be seen in:
- Hepatic disease
- Shear injury
- Iron deficiency
- Portosystemic shunts
Keratocytes and schistocytes also occur with these conditions

DDx for shear injury
Haemangiosarcoma
Vasculitis
DIC
Endocarditis
Heart disease
Glomerulonephritis
Thrombosis
What are the main causes of eccinocyte formation?
These form due to drying or dehydration of the RBC.
This mot commonly occurs as a slide preparation artifact but can also occur with ureamia and electrolyte imbalances
What RBC morphologic changes are associated with oxidative membrane damage.
Eccenterocytes
Heinz bodies (see picture)

DDx oxidative damage anaemia
Allium toxicity
Paracetamol toxicity
Propofol
Ketoacidosis
Lymphoma
Vitamin K toxicity
Propylene glycol
Hyperthyroidism
How is the corrected Rt % calculated?
Rt% = patient PCV/normal PCV
What are the components of the stress leukogram
Segmented
Monocytes
Increased
Lymphocytes
Eosinophils
Decreased


